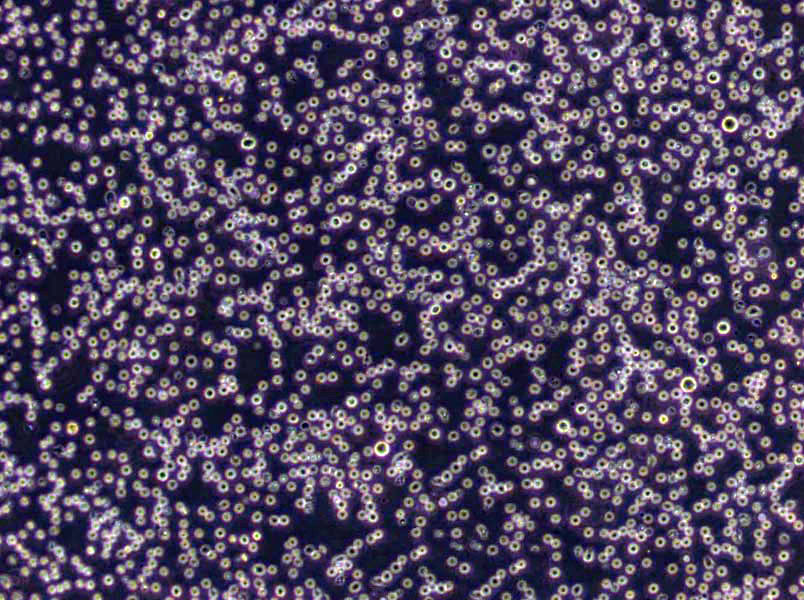
嗜热脂肪杆菌恢复琼脂基础培养基

"嗜热脂肪杆菌恢复琼脂基础培养基
产品规格:250g/瓶
英文名称:Bacillus Stearothermophilus Recovery Agar Medium
培养基的质量测试:每批培养基制备好以后,应仔细一遍,如发现破裂、水分浸入、色泽异常、棉塞被培养基沾染等、均应挑出弃去。并测定其最终pH。将全部培养基放入36±1°C恒温箱培养过夜,如发现有菌生长,即弃去。用有关的标准菌株接种1~2管或瓶培养基,培养24~48小时,如无菌生长或生长不好。应追查原因并重复接种一次,如结果仍同前,则该批培养基即应弃去,不能使用。培养基的保存:培养基应存放于冷暗处,能放于普通冰箱内。放置时间不宜超过一周,倾注的平板培养基不宜超过3天。每批培养基均必须附有该批培养基制备记录副页或明显标签。培养基成分的称取:培养基的各种成分必须精确称取并要注意防止错乱,一次完成,不要中断。可将配方置于一侧,每称完一种成分即在配方面均做出记号,并将所需称取的药品一次取齐,置于左侧,每种称取完毕后,即移放于右侧。完全称取完毕后,还应进行一次。
麦康凯[MAC]肉汤培养基英文名称:MacConkey Broth(CT-MAC Broth Base)
麦氏[Meclary]琼脂培养基英文名称:Meclary Agar
Pfizer肠球菌选择性琼脂培养基英文名称:Pfizer Enterococcus Selective Agar
改良Gorodkowa琼脂培养基英文名称:Modified Gorodkowa Agar
产品用途:用于灭菌与消毒鉴定试验
嗜热脂肪杆菌恢复琼脂基础培养基
微生物培养基的分类:1、按照培养基用途分为培养基按其特殊用途可分为加富培养基、选择性培养基和鉴别培养基。2、按照培养基的成分来分:培养基按其所含成分,可分为合成培养基、天然培养基和半合成培养基三类。合成培养基:合成培养基的各种成分完全是已知的各种化学物质。这种培养基的化学成分清楚,组成成分精确,重复性强,但价格较贵,而且微生物在这类培养基中生长较慢。如高氏一号合成培养基、察氏(Czapek)培养基等。天然培养基:由天然物质制成,如蒸熟的马铃薯和普通牛肉汤,前者用于培养霉菌,后者用于培养细菌。这类培养基的化学成分很不恒定,也难以确定,但配制方便,营养丰富,培养效果好,所以常被采用。半合成培养基:在天然有机物的基础上适当加入已知成分的无机盐类或在合成培养基的基础上添加某些天然成分,如培养霉菌用的马铃薯葡萄糖琼脂培养基。这类培养基能更有效地满足微生物对营养物质的需要。3、按照培养基的物理状态分:培养基按其物理状态可分为固体培养基、夜体培养基和半固体培养基三类。固体培养基:是在培养基中加入凝固剂,有琼脂、明胶、硅胶等。固体培养基常用于微生物分离、鉴定、计数和菌种保存等方面。用于微生物分离,鉴定,计数。如图,微生物分离成菌落、菌苔。图中为大肠杆菌菌落,是用涂布平板法得到。半固体培养基:是在夜体培养基中加入少量凝固剂而呈半固体状态。可用于观察细菌的运动、鉴定菌种和测定噬菌体的效价等方面。用于观察微生物运动特征。如图,左侧试管中微生物不运动,而右侧试管中微生物运动,因而两试管中现象不同。夜体培养基:夜体培养基中不加任何凝固剂。这种培养基的成分均匀,微生物能充分接触和利用培养基中的养料,适于作生理等研究,由于发酵率高,操作方便,也常用于发酵工业。用于观察微生物生长状态。3、按照微生物的种类分:培养基按微生物的种类可分为细菌培养基、放线菌培养基、酵母菌培养基和霉菌培养基等四类
改良牛津培养基英文名称:Modified Oxford Medium Base
安苄青霉素麦康凯琼脂培养基英文名称:Ampicillin MacConey Agar Base
MH肉汤培养基英文名称:Mueller-Hinton Broth
胱安酸乳糖无电解质培养基英文名称:C.L.E.D Medium
梭菌增菌培养基英文名称:Clostridium Enrichment Medium
使用说明:称取本品35.0g于1L蒸馏水或去离子水中,加热煮沸至完全溶解,分装,121℃高压灭菌15分钟或115℃灭菌30分钟,灭菌结束后请摇匀,以防琼脂沉积于器皿底部而凝固,备用。
公司目前是微生物培养基专业、权威生产商,产品种类达到2800余种。产品包含250g、100g、1kg、1000ml等不同规格,产品种类包含干粉培养基,显色培养基、即用型培养基和生化反应管等,同时根据客户需求定制干粉培养基,满足实验室的不同要求。公司通过了ISO9001-2008国际质量管理体系认证。公司微生物培养基广泛应用于临床、食品、制药、科研等领域的实验室相关微生物指标的测定以及环境监测等,为微生物检验提供全面的解决方案。公司严格控制产品质量,从干粉外观、pH、凝胶强度、透明度、灵敏度、生长率、假阴性、假阳性、生长特征等方面严格把关。参照国家标准GB、中国药典(CP)、欧洲药典(EP)、药典(USP)和其它标准如ISO、JP所提及的成分配比进行生产。公司拥有成熟的研发团队和先进的生产设备,确保产品的技术先进性和质量稳定性。
三丁酸酯琼脂培养基;英文名称:Tributyrin Agar Base;产品别名:三丁酸酯琼脂培养基基础;三丁酸酯琼脂培养基;使用说明:称取本品4.0g于200ml蒸馏水或去离子水中,添加1支三丁酸酯,加热煮沸至完全溶解,121℃高压灭菌 20 分钟,灭菌结束后请摇匀,以防琼脂沉积于器皿底部而凝固,备用;产品规格:250g/瓶;产品用途:用于脂解细菌的检验和计数。每200ml添加1支三丁酸酯
赖安酸培养基;英文名称:Lysine Medium;产品别名:赖安酸培养基基础;LYS培养基;赖安酸培养基(LYS);使用说明:称取本品6.6g于100ml蒸馏水或去离子水中,加入50%乳酸钾溶夜1ml,持续煮沸分钟使彻底溶解,冷却至50℃,加入10%乳酸溶夜0.1ml调节pH使达到4.8±0.2,倾注平板,凝固,备用;产品规格:600g/瓶;产品用途:用于啤酒野生酵母检验,需添加乳酸钾并使用乳酸校正酸碱度
硫酸盐还原菌培养基F;英文名称:Postgate’s Medium F for Sulfate Reducers;产品别名:硫酸盐还原菌培养基基础F;硫酸盐还原菌培养基F;使用说明:NULL;产品规格:250g/瓶;产品用途:含琼脂,用于脱硫微生物的培养和计数,每100ml添加1支35%乳酸钠溶夜
酪安酸琼脂培养基;英文名称:ISP Medium 7( Tyrosine Agar Medium Base);产品别名:酪安酸琼脂培养基基础;酪安酸琼脂培养基;使用说明:称取本品18.5g及15g于1L去离子水或30%海水中,煮沸溶解,分装,121℃高压灭菌15分钟,灭菌结束后请摇匀,以防琼脂沉积于底部而凝固;产品规格:250g/瓶;产品用途:用于链霉菌属的培养鉴定,每200ml添加3支
溶血琼脂培养基;英文名称:Hemolysis Agar Base;产品别名:溶血琼脂培养基基础;溶血琼脂培养基;使用说明:称取本品33.0克,溶解于1000ml蒸馏水中,121℃高压灭菌15分钟,冷却至50-55℃时,加入无菌的兔脱纤维溶血夜10ml,混匀,倾入无菌平皿,备用;产品规格:250g/瓶;产品用途:用于鼠疫杆菌的培养,需添加无菌脱纤维绵羊全血
TYC肉汤培养基;英文名称:Tryptone Yeast Cystine Broth Medium;产品别名:TYC肉汤培养基基础;TYC肉汤培养基;使用说明:称取本品86.0g于1L蒸馏水或去离子水中(可按比例增加或减少配制量),加热煮沸至完全溶解,分装,121℃高压灭菌15分钟,冷却,备用。如有需要,本品可选择性添加杆菌肽0.2U/ml以增加选择性;产品规格:250g/瓶;产品用途:用于血链球菌的分离,每100ml可选择性添加1支多粘菌素B溶夜以增加选择性
麦芽汁肉汤培养基;英文名称:Malt Extract Broth;产品别名:麦芽汁肉汤培养基基础;麦芽汁肉汤培养基;使用说明:称取本品15.0g于1L蒸馏水或去离子水中,微温溶解,分装,121℃高压灭菌15分钟,备用;产品规格:250g/瓶;产品用途:含0.6%麦芽浸粉,不含Cl霉素,用于霉菌和酵母菌的培养
硫乙醇酸盐培养基[Brewer];英文名称:Thioglycollate Medium (Brewer);产品别名:硫乙醇酸盐培养基基础[Brewer];硫乙醇酸盐培养基[Brewer];使用说明:称取本品20.1g于1L蒸馏水或去离子水中,加热煮沸至完全溶解,分装,121℃高压灭菌15分钟或115℃灭菌30分钟,灭菌结束后请摇匀并迅速冷却,备用;产品规格:250g/瓶;产品用途:以美蓝/亚甲基蓝为指示剂,用于厌氧菌培养
营养葡萄糖琼脂培养基;英文名称:Nutrient Glucose Agar(Waksman, 1957);产品别名:营养葡萄糖琼脂培养基基础;NGA培养基;营养葡萄糖琼脂培养基(NGA);使用说明:NULL;产品规格:250g/瓶;产品用途:用于链霉菌属的培养鉴定
Karmali氏弯曲杆菌琼脂培养基;英文名称:Karmali’s Campylobacter Medium;产品别名:Karmali氏弯曲杆菌琼脂培养基基础;Karmali氏弯曲杆菌琼脂培养基;使用说明:称取本品43.0g于1L蒸馏水或去离子水中,加热煮沸1分钟以上使彻底溶解,分装,121℃高灭菌15分钟,冷至50-55℃,无菌操作每100ml添加1支Karmali氏弯曲杆菌琼脂培养基添加剂,混匀,倾注平皿,备用;产品规格:500g/瓶;产品用途:用于弯曲菌的选择性分离培养,每100ml添加1支Karmali氏弯曲杆菌琼脂培养基添加剂
甘露醇盐琼脂培养基 ;英文名称:Mannitol Salt Agar;产品别名:甘露醇盐琼脂培养基基础 ;甘露醇盐琼脂培养基 ;使用说明:称取本品110.0g于1L蒸馏水或去离子水中,煮沸溶解1分钟,补水至1000ml,分装,121℃灭菌15分钟或116℃30分钟,灭菌结束后请摇匀以防琼脂沉底于底部而凝固,冷至55℃左右,备用;产品规格:250g/瓶;产品用途:用于金黄色葡萄球菌选择性分离(日本标准)
乳酸杆菌选择性肉汤培养基;英文名称:Lactobacillus Selective Broth;产品别名:乳酸杆菌选择性肉汤培养基基础;LBS肉汤;乳酸杆菌选择性肉汤培养基(LBS);使用说明:称取本品59.8克,于1000ml蒸馏水中,并吸取1.32ml冰乙酸,混匀,加热溶解并不停搅拌,冷至50℃左右时,倾入无菌平皿,无需高压灭菌;产品规格:250g/瓶;产品用途:用于乳酸菌的选择性培养,每升需添加1.32ml冰乙酸
假单胞菌分离琼脂培养基;英文名称:Pseudomonas Isolation Agar;产品别名:假单胞菌分离琼脂培养基基础;假单胞菌分离琼脂培养基;使用说明:称取本品45.0g于1L含2%的蒸馏水或去离子水中(可按比例增加或减少配制量),加热持续煮沸1分钟以上使完全溶解,分装,121℃高压灭菌15分钟,备用;产品规格:250g/瓶;产品用途:用于假单胞菌的检验,每升培养基中添加20ml
赖安酸脱羧酶试验培养基;英文名称:Lysine-decarboxylase Test Medium;产品别名:赖安酸脱羧酶试验培养基基础;赖安酸脱羧酶试验培养基;使用说明:称取本品14.0g于1L蒸馏水或纯化水中,加热煮沸至完全溶解,分装小试管,每管滴加1层约0.5ml夜体石蜡,116℃高压灭菌10分钟或115℃灭菌15分钟,备用;产品规格:100g/瓶;产品用途:用于细菌的赖安酸脱羧酶试验
APA培养基;英文名称:APA Medium Base;产品别名:APA培养基基础;APA培养基;使用说明:称取本品64.0g于900ml蒸馏水或去离子水中,煮沸溶解1分钟,补水至1000ml,分装,121℃灭菌15分钟,冷至55℃左右,加入10%无菌碳酸钠溶夜100ml,混匀,调节pH9.8±0.2(25℃),备用;产品规格:250g/瓶;产品用途:用于嗜盐菌的培养,灭菌后需添加1%无菌碳酸钠
脱脂奶蔗糖蛋白胨培养基;英文名称:Skimmed Milk Sucrose Peptone Medium Base;产品别名:脱脂奶蔗糖蛋白胨培养基基础;脱脂奶蔗糖蛋白胨培养基;使用说明:称取本品46.5g于1L蒸馏水或去离子水中(可按比例增加或减少配制量),加热煮沸至完全溶解,分装,121℃高压灭菌15分钟,灭菌结束后请摇匀,以防琼脂沉积于器皿底部而凝固,备用;产品规格:250g/瓶;产品用途:用于致病性嗜水气单胞菌的鉴别,每100ml添加1支20%脱脂奶粉溶夜
曲霉菌基本培养基;英文名称:Aspergillus Minimal Medium;产品别名:曲霉菌基本培养基基础;AAM培养基;曲霉菌基本培养基(AAM);使用说明:称取本品18.72g于1L蒸馏水或去离子水中,微温溶解,分装,121℃高压灭菌15分钟,备用。本品可能有少量不溶物,视需要添加琼脂、抗生素、糖等其它物质;产品规格:250g/瓶;产品用途:用于曲霉菌的培养
WL营养肉汤培养基;英文名称:Wallerstein Laboratory Nutrient Broth;产品别名:WL营养肉汤培养基基础;WL营养肉汤培养基;使用说明:称取本品60.0g于1L蒸馏水或去离子水中,微温溶解,分装,121℃高压灭菌15分钟,冷却,备用;产品规格:250g/瓶;产品用途:用于啤酒和发酵产品中酵母菌和细菌的培养
1%吐温80-玉米琼脂培养基;英文名称:1% Tween80-Corn Meat Agar Medium Base;产品别名:1%吐温80-玉米琼脂培养基基础;1%吐温80-玉米琼脂培养基;使用说明:称取本品2.2g于100ml蒸馏水或去离子水中,添加1支1ml吐温80,121℃高压灭菌15分钟或115℃灭菌30分钟,冷却至45~50℃,倾注平板;产品规格:100g/瓶;产品用途:用于白色念珠菌产芽管试验,每100ml添加1ml吐温80
西蒙氏柠檬酸盐肉汤培养基;英文名称:Simmons Citrate Broth;产品别名:西蒙氏柠檬酸盐肉汤培养基基础;枸橼酸盐肉汤;西蒙氏柠檬酸盐肉汤培养基;使用说明:称取本品12.3g于1L蒸馏水或去离子水中,加热溶解,分装试管,121℃高压灭菌15分钟,冷却,备用;产品规格:250g/瓶;产品用途:用于柠檬酸盐利用实验
改良CCD琼脂培养基;英文名称:Modified CCD Agar Base;产品别名:改良CCD琼脂培养基基础;改良CCD琼脂培养基;使用说明:称取本品51.5g于1L蒸馏水或去离子水,加热煮沸1分钟以上使彻底溶解,分装试管,121℃高压灭菌15分钟,冷至45-50℃,每100ml培养基添加1支弯曲菌分离琼脂添加剂(头孢哌酮、两性霉素B、利福平),混匀,倾注平皿,凝固,备用;产品规格:250g/瓶;产品用途:用于弯曲菌选择性分离,每100ml添加1支 弯曲菌分离琼脂添加剂(头孢哌酮、两性霉素B、利福平)
铋[BS]琼脂培养基;英文名称:Bismuth Sulfite Agar;产品别名:铋[BS]琼脂培养基基础;铋[BS]琼脂培养基;使用说明:称取本品5.03g于100ml蒸馏水或去离子水中,搅拌煮沸溶解1分钟,定容,冷却至50~55℃倾注平板。建议每次配制不超过200ml,配制后隔夜使用且在3天内用完;产品规格:250g/瓶;产品用途:用于沙门氏菌选择性分离
嗜热脂肪杆菌恢复琼脂基础培养基
厌氧琼脂培养基;英文名称:Anaerobe Basal Agar;产品别名:厌氧琼脂培养基基础;厌氧琼脂培养基;使用说明:称取本品46.0于1L蒸馏水或去离子水(也可按比例增加或减少配制量),加热煮沸持续1分钟以上使溶解,分装,121℃高压灭菌15分钟,冷至50-55℃,无菌操作添加5-10%的脱纤维马血或羊血,轻轻混匀,倾注平板,凝固,备用;产品规格:250g/瓶;产品用途:用于厌氧菌尤其是拟杆菌的培养,需添加5-10%无菌脱纤维绵羊全血
M17琼脂培养基;英文名称:M17 Agar;产品别名:M17琼脂培养基基础;M17琼脂培养基;使用说明:称取本品4.83g于95ml蒸馏水或去离子水中,加热煮沸至完全溶解,分装121℃高压灭菌15分钟,冷至55℃,无菌操作加入无菌的10%乳糖溶夜5ml,混匀,倾注平皿,备用;产品规格:250g/瓶;产品用途:用于牛奶和乳制品中乳酸菌检测及分离被噬菌体感染的乳酸菌,每100ml添加1支10%乳糖溶夜
产芽孢肉汤培养基;英文名称:Sporulation Broth;产品别名:产芽孢肉汤培养基基础;产芽孢肉汤培养基;使用说明:称取本品33.0g,加热溶解于1000ml蒸馏水中,分装试管,每管15ml,121℃高压灭菌15分钟,备用;产品规格:250g/瓶;产品用途:用于产气荚膜梭菌的芽孢试验
Andrade氏糖类肉汤培养基;英文名称:Andrade′s Carbohydrate Broth Base;产品别名:Andrade氏糖类肉汤培养基基础;Andrade氏糖类肉汤培养基;使用说明:称取本品23.1g,另称取糖类或醇类(葡萄糖、乳糖、蔗糖、甘露醇按10g称取;其他糖类或醇类按5g称取),加热溶解于1000ml蒸馏水中,分装试管,121℃高压灭菌15分钟,备用。注:若培养基颜色偏红,可滴加几滴1N NaOH溶夜脱色后,再高压灭菌;产品规格:250g/瓶;产品用途:用于细菌的糖发酵试验,需加糖
支原体固体培养基;英文名称:Mycoplasma Agar Medium Base;产品别名:支原体固体培养基基础;支原体固体培养基;使用说明:称取本品40.50g,加热溶解于800ml蒸馏水中,121℃高压灭菌15分钟,冷至45-50℃时,无菌操作加入灭活小牛血清或马血清200ml和青霉素80万单位,混匀,倾入无菌平皿,备用;产品规格:250g/瓶;产品用途:需添加马血清、MEM 培养夜、青霉素和
萨氏夜体培养基;英文名称:Sabouraud Dextrose Medium with Yeast Extract;产品别名:萨氏夜体培养基基础;SDY培养基;萨氏夜体培养基(SDY);使用说明:称取本品60.0g于1L蒸馏水或去离子水中,加热煮沸至完全溶解,分装,115℃灭菌30分钟,备用;产品规格:250g/瓶;产品用途:用于真菌的培养
GAM半固体培养基[不含葡萄糖];英文名称:Glfu Anaerobic Medium Semisolid without Dextrose;产品别名:GAM半固体培养基基础[不含葡萄糖];GAM半固体培养基[不含葡萄糖];使用说明:NULL;产品规格:250g/瓶;产品用途:用于厌氧菌的保存
CFAT琼脂培养基;英文名称:Cadmium Sulfate Fluoride Acridine Trypticase Agar;产品别名:CFAT琼脂培养基基础;CFAT琼脂培养基;使用说明:NULL;产品规格:250g/瓶;产品用途:用于内氏放线菌和粘性放线菌的分离培养,每100ml添加黄溶夜、碱性复红溶夜各1支
改良NBB琼脂培养基;英文名称:NBB Agar Base,Modified;产品别名:改良NBB琼脂培养基基础;改良NBB琼脂培养基;使用说明:称取本品66.3g,加入500ml蒸馏水和500ml脱气啤酒中,加热搅拌溶解,煮沸1分钟,使其彻底溶解,121℃高压灭菌15分钟,备用;产品规格:250g/瓶;产品用途:用于啤酒中厌氧菌的检测
动力-硝酸盐培养基[B法];英文名称:Power-nitrate Medium;产品别名:动力-硝酸盐培养基基础[B法];动力-硝酸盐培养基[B法];使用说明:称取本品23.5.0g于1L蒸馏水或去离子水(也可按比例增加或减少配制量),另加入5ml,加热煮沸1分钟以上使彻底溶解,分装试管,121℃高压灭菌15分钟,直立,凝固,备用;产品规格:250g/瓶;产品用途:用于细菌动力和硝酸盐还原试验,每100ml添加1ml
脑心浸出夜肉汤培养基;英文名称:Brain Heart Infusion Broth;产品别名:脑心浸出夜肉汤培养基基础;BHI/BHIB培养基;脑心浸出夜肉汤培养基(BHI/BHIB);使用说明:称取本品37.0g于1L蒸馏水或去离子水中,煮沸溶解,分装,121℃高压灭菌15分钟,冷却,备用;产品规格:250g/瓶;产品用途:用于细菌尤其是葡萄球菌的增菌和培养(SN/ISO)
果蝇培养基;英文名称:Drosophila Medium;产品别名:果蝇培养基基础;果蝇培养基;使用说明:称取本品20.87g于100ml蒸馏水中,小火搅拌煮沸溶解1分钟,注意泡沫较多,防止外溢,补足水分,待稍冷加入0.65ml混匀,趁热将培养基装入已灭菌的培养瓶中,备用;产品规格:250g/瓶;产品用途:用于果蝇的培养,每150ml添加1ml
1%葡萄糖肉汤培养基;英文名称:1% Dextrose Broth Medium;产品别名:1%葡萄糖肉汤培养基基础;1%葡萄糖肉汤培养基;使用说明:称取本品28.0g于1L蒸馏水或去离子水中,微温溶解,分装,121℃高压灭菌15分钟或115℃灭菌30分钟,备用;产品规格:250g/瓶;产品用途:用于初次分离细菌的增菌培养
四酸钠亮绿培养基;英文名称:Tetrathionate Broth Base;产品别名:四酸钠亮绿培养基基础;TTB培养基;四酸钠亮绿培养基(TTB);使用说明:称取本品46.0g于1L蒸馏水或去离子水中,加热煮沸,分装,121℃高压灭菌15分钟或115℃高压灭菌30分钟,冷却,冷暗储存备用。临用前,每100ml加入碘溶夜、0.1%煌绿溶夜各一支,混合均匀,边摇匀边分装;产品规格:250g/瓶;产品用途:用于沙门氏菌选择性增菌,每100ml添加碘溶夜、0.1%煌绿溶夜各1支
酵母浸出粉胨葡萄糖琼脂培养基;英文名称:Yeast Extract Peptone Dextrose Agar;产品别名:酵母浸出粉胨葡萄糖琼脂培养基基础;YPD培养基;酵母浸出粉胨葡萄糖琼脂培养基(YPD);使用说明:称取本品49.0g于1L蒸馏水或去离子水中,加热至完全溶解,分装,115℃高压灭菌30分钟,灭菌结束后请摇匀,以防琼脂沉积于器皿底部而凝固,备用;产品规格:250g/瓶;产品用途:用于真菌计数
假单胞菌琼脂培养基P;英文名称:Pseudomonas Agar for Detection of Pyocyanin;产品别名:假单胞菌琼脂培养基基础P;假单胞菌琼脂培养基P;使用说明:称取本品4.64g于100mL蒸馏水或去离子水中,添加1支1mL,加热搅拌煮沸至完全溶解,分装,121℃高压灭菌15分钟,灭菌结束后请摇匀,以防琼脂沉积于器皿底部而凝固,备用;产品规格:250g/瓶;产品用途:用于假单胞菌绿脓菌素测定,每100ml添加1ml
西蒙氏柠檬酸盐琼脂培养基;英文名称:Simmons Citrate Agar;产品别名:西蒙氏柠檬酸盐琼脂培养基基础;枸橼酸盐琼脂;西蒙氏柠檬酸盐琼脂培养基;使用说明:称取本品32.3g于1L蒸馏水或去离子水中,加热煮沸至溶解,分装试管,121℃高压灭菌15分钟,摆斜面,凝固,备用;产品规格:250g/瓶;产品用途:用于柠檬酸盐利用实验
蛋白胨山梨醇胆盐[PSB]肉汤培养基;英文名称:Peptone Sorbitol Bile salts Broth;产品别名:蛋白胨山梨醇胆盐[PSB]肉汤培养基基础;蛋白胨山梨醇胆盐[PSB]肉汤培养基;使用说明:称取本品30.93g于1L蒸馏水或去离子水中,微温溶解,分装,121℃高压灭菌15分钟,冷却,备用;产品规格:250g/瓶;产品用途:用于耶尔森氏菌选择性增菌
OGY琼脂培养基;英文名称:Oxytetracycline Glucose Yeast Agar;产品别名:OGY琼脂培养基基础;OGY琼脂培养基;使用说明:称取本品15.0克,加热溶解于500ml蒸馏水中,121℃高压灭菌15分钟,冷至50-55℃时,无菌操作加入过滤除菌土霉素50mg,混匀,倾注无菌平皿;产品规格:250g/瓶;产品用途:用于霉菌、酵母菌计数,葡萄糖10g/L,每100ml添加1支盐酸土霉素溶夜
EB肉汤增菌夜培养基;英文名称:EB Enrichment Broth;产品别名:EB肉汤增菌夜培养基基础;EB肉汤增菌夜培养基;使用说明:NULL;产品规格:250g/瓶;产品用途:用于李斯特氏菌的选择性增菌,每225ml添加1支黄溶夜、2支萘啶酮酸溶夜、1支溶夜
抗生素培养基1号;英文名称:Medium 1(Penassay Seed Agar);产品别名:抗生素培养基基础1号;抗生素培养基1号;使用说明:称取本品30.5g于1L蒸馏水或去离子水中,加热煮沸至完全溶解,分装,121℃高压灭菌15分钟或115℃灭菌30分钟,灭菌结束后请摇匀,备用;产品规格:250g/瓶;产品用途:用于微生物方法测定抗生素效价
嗜冷菌计数琼脂培养基;英文名称:Psychrophilic Bacterium Count Agar;产品别名:嗜冷菌计数琼脂培养基基础;嗜冷菌计数琼脂培养基;使用说明:称取本品24.5g于1L蒸馏水或去离子水中(可按比例增加或减少配制量),加热煮沸至完全溶解,分装,121℃高压灭菌15分钟,灭菌结束后请摇匀,以防琼脂沉积于器皿底部而凝固,备用;产品规格:250g/瓶;产品用途:用于乳制品中嗜冷微生物的培养
结晶紫中性红胆盐琼脂培养基[含葡萄糖和乳糖];英文名称:Violet Red Bile Agar with Glucose and Lactose;产品别名:结晶紫中性红胆盐琼脂培养基基础[含葡萄糖和乳糖];结晶紫中性红胆盐琼脂培养基[含葡萄糖和乳糖];使用说明:称取本品51.5g于1L蒸馏水或去离子水中(可按比例增加或减少配置量),搅拌煮沸溶解1分钟,冷却至50-55℃倾注平板;产品规格:250g/瓶;产品用途:用于肠道菌选择性分离和计数
巧克力血琼脂培养基;英文名称:Chocolate Blood Agar Medium Base;产品别名:巧克力血琼脂培养基基础;巧克力血琼脂培养基;使用说明:称取本品43.0g于1L蒸馏水或去离子水中,加热煮沸至完全溶解,分装,121℃高压灭菌15分钟,于90℃添加5-10%脱纤维羊血,摇匀,继续加热保温,边加热边摇动,直至分层,冷至50℃,摇匀,倾注平板;产品规格:250g/瓶;产品用途:用于奈瑟球菌、流感嗜血杆菌的培养,需添5%~10%无菌脱纤维绵羊全血
3%NaCl甘露醇发酵培养基;英文名称:Mannitol Fermentation Medium with 3%Nacl;产品别名:3%NaCl甘露醇发酵培养基基础;3%NaCl甘露醇发酵培养基;使用说明:NULL;产品规格:250g/瓶;产品用途:用于弧菌的甘露醇发酵试验
Cl化钠结晶紫增菌夜培养基;英文名称:Sodium Chloride Violet purple Enrichment Broth;产品别名:Cl化钠结晶紫增菌夜培养基基础;Cl化钠结晶紫增菌夜培养基;使用说明:称取本品60.0g,加热溶解于1000ml蒸馏水中,分装,121℃高压灭菌15分钟,备用;产品规格:250g/瓶;产品用途:用于副溶血性弧菌的选择性增菌
MKTTn肉汤培养基;英文名称:Muller Kauffmann Tetrathionate Novobiocin Broth Ba;产品别名:MKTTn肉汤培养基基础;MKTTn肉汤培养基;使用说明:称取本品89.5g,加热溶解于1000ml蒸馏水中,迅速冷却,此溶夜在2-8℃可保存4周,临用前加入20ml碘夜(5g碘溶解于2ml蒸馏水,然后加入4g碘,加蒸馏水至20ml),混匀,分装试管,每管10ml,当天制备当天使用,无需高压灭菌;产品规格:250g/瓶;产品用途:用于沙门氏菌增菌,每100ml中添加1支碘溶夜和2支新生霉素储备夜
营养肉汤培养基;英文名称:Nutrient Broth;产品别名:营养肉汤培养基基础;NB培养基;营养肉汤培养基(NB);使用说明:称取本品18.0g于1L蒸馏水或去离子水中,微温溶解,分装,121℃高压灭菌15分钟或115℃灭菌30分钟,备用。若配制亚碲酸盐肉汤培养基,冷却至50~55℃,每100ml培养基中需添加1支亚碲酸钾溶夜;若配制TTC营养肉汤,冷却至50~55℃,每100ml培养基中需添加1支1%TTC溶夜;产品规格:250g/瓶;产品用途:用于细菌的培养和增菌
沙堡夜体培养基;英文名称:Sabouraud’s Broth Medium;产品别名:沙堡夜体培养基基础;沙堡夜体培养基;使用说明:称取本品50.0g于1L蒸馏水或去离子水中,微温溶解,分装,115℃灭菌30分钟,冷却,备用;产品规格:250g/瓶;产品用途:用于真菌杀灭试验
药敏试验琼脂培养基;英文名称:Sensitivity Disk Agar;产品别名:药敏试验琼脂培养基基础;药敏试验琼脂培养基;使用说明:称取本品38.1g于1L蒸馏水或去离子水中(可按比例增加或减少配制量),加热煮沸至完全溶解,分装,115℃高压灭菌15分钟,灭菌后请摇匀,以防琼脂沉淀于器皿底部而凝固,备用;产品规格:250g/瓶;产品用途:用于抗生素药敏试验
碎肉葡萄糖肉汤培养基;英文名称:Chopped Meat Glucose(CMG);产品别名:碎肉葡萄糖肉汤培养基基础;碎肉葡萄糖肉汤培养基;使用说明:NULL;产品规格:250g/瓶;产品用途:用于厌氧菌特别是专性厌氧菌的培养,含VK ,需添加庖肉牛肉粒
菌种培养基;英文名称:Strain Medium;产品别名:菌种培养基基础;菌种培养基;使用说明:称取本品31.5克,加热溶解于1000ml蒸馏水中,121℃高压灭菌15分钟,备用;产品规格:250g/瓶;产品用途:用于菌种培养与保存(pH6.5)
Br紫肉汤培养基;英文名称:Purple Broth Base;产品别名:Br紫肉汤培养基基础;Br紫肉汤培养基;使用说明:NULL;产品规格:250g/瓶;产品用途:用于细菌的分离和鉴别,需选择性添加0.5-1%碳源
氧化亚铁硫杆菌培养基;英文名称:Thiobacillus Ferrooxidans Medium;产品别名:氧化亚铁硫杆菌培养基基础;氧化亚铁硫杆菌培养基;使用说明:称取本品48.31g于1L蒸馏水或去离子水中,加热煮沸至完全溶解,分装,121℃高压灭菌15分钟,冷却,备用;产品规格:250g/瓶;产品用途:用于氧化亚铁硫杆菌和其它铁细菌的培养
煌绿磺胺嘧啶琼脂培养基;英文名称:Brilliant Green Agar with Sulfadiazine;产品别名:煌绿磺胺嘧啶琼脂培养基基础;BGS琼脂培养基;煌绿磺胺嘧啶琼脂培养基(BGS);使用说明:称取本品59.0g于1L蒸馏水或去离子水中,搅拌煮沸溶解1分钟使完全溶解,定容,分装,121℃灭菌15分钟,灭菌结束后请摇匀,以防琼脂沉积于器皿底部而凝固。冷却至55℃左右,倾注平板,备用;产品规格:250g/瓶;产品用途:含磺胺嘧啶,用于沙门氏菌的选择性分离
葡萄糖蛋白胨琼脂培养基[不含中和剂];英文名称:DT Medium;产品别名:葡萄糖蛋白胨琼脂培养基基础[不含中和剂];DT培养基;葡萄糖蛋白胨琼脂培养基[不含中和剂];使用说明:称取本品31.0g于1L蒸馏水或去离子水中,(若配制含中和剂的DT培养基,每升培养基中还需添加1支7g吐温-80,加热煮沸至完全溶解,分装,121℃高压灭菌15分钟,灭菌结束后请摇匀,以防琼脂沉积于器皿底部而凝固,备用;产品规格:250g/瓶;产品用途:用于需氧芽孢杆菌计数
马铃薯-葡萄糖-琼脂培养基[不含Cl霉素]英文名称:Potato Dextrose Agar Medium(PDA)
我妻氏血琼脂培养基英文名称:Wagstsuma Blood Agar Base
Eugon LT 100肉汤培养基英文名称:Eugon LT 100 Broth Base
尿素琼脂培养基[pH7.2]英文名称:Urease Agar Base
改良R2A琼脂培养基英文名称:R2A Agar, Modified
MH肉汤培养基Ⅱ[阳离子调节]英文名称:Mueller Hinton Ⅱ Broth(Cation-Adjusted)/CAMHB
ER培养基英文名称:ER Medium
YPDA琼脂培养基英文名称:Yeast Peptone Dextrose Adenine Agar
酵母安基酸缺陷型合成夜体培养基[尿嘧啶缺陷]英文名称:Yeast Synthetic Drop-out Fluid Medium without Urac
高盐察氏培养基英文名称:Salt Czapek Dox Medium
PPLO肉汤培养基英文名称:PPLO Broth Base
CW琼脂培养基[不含卡那霉素]英文名称:Clostridium Welchii Agar Base without Kanamycin
MH肉汤培养基Ⅱ[阳离子调节]英文名称:Mueller Hinton Ⅱ Broth(Cation-Adjusted)/CAMHB
维生素B12测定用培养基英文名称:Vitamin B12 Assay Broth
改良GAM肉汤培养基英文名称:Glfu Anaerobic Medium Broth Base,Modified
亮绿琼脂培养基英文名称:Brilliant Green-Agar Medium
抗生素培养基1号英文名称:Medium 1(Penassay Seed Agar)
脒多粘菌素琼脂培养基英文名称:Pentane Amidines Polymyxin Agar Base
溶菌酶多粘菌素琼脂培养基英文名称:Lysozyme Polymyxin Agar Base
结晶紫中性红胆盐琼脂培养基[含葡萄糖和乳糖]英文名称:Violet Red Bile Agar with Glucose and Lactose
AAM培养基英文名称:AAM Medium
细菌保存培养基英文名称:Bacteria Save Medium
Waksman夜体培养基英文名称:Waksman Medium
洋葱假单胞菌琼脂培养基英文名称:Pseudomonas Cepacia Agar Base
SBG肉汤培养基英文名称:Selenite Brilliant Green Broth
麦芽糖酵母浸粉琼脂培养基英文名称:Maltose yeast extract agar (Okazaki and Okami, 197
孟加拉红培养基英文名称:Rose Bengal Medium
BCYE琼脂培养基英文名称:Buffered Charcoal Yeast Extract Agar Base
西蒙氏柠檬酸盐琼脂培养基英文名称:Simmons Citrate Agar
嗜热脂肪杆菌恢复琼脂基础培养基
酸性肉汤培养基英文名称:Acid Broth
酸性番茄培养基英文名称:Acid Tomato Juice Medium
m-TGE肉汤培养基英文名称:m-TGE Broth
酵母安基酸缺陷型合成夜体培养基[色安酸缺陷]英文名称:Yeast Synthetic Drop-out Fluid Medium without Try
含0.2%可溶性淀粉的BCP脱脂奶粉平板计数培养基英文名称:BCP Medium with 0.2% Soluble Starch
念珠菌显色培养基英文名称:Candida Chromogenic Medium
番茄汁特制琼脂培养基英文名称:Tomato Juice Agar Special
麦康凯琼脂培养基英文名称:MacConey Agar Medium
酵母菌形态琼脂培养基英文名称:Yeast Morphology Agar
结晶紫中性红胆盐琼脂培养基[含葡萄糖和乳糖]英文名称:Violet Red Bile Agar with Glucose and Lactose
GAM半固体培养基英文名称:Glfu Anaerobic Medium Semisolid
LAPTg肉汤培养基英文名称:LAPTg Broth
木本植物用培养基英文名称:Lloyd & McCown’s Woody Plant Medium
SB琼脂培养基英文名称:Super Broth Agar
伊红美蓝琼脂培养基[不含乳糖]英文名称:Levine’s Eosin-Methylene Blue Agar without Lactose
MS培养基[不含琼脂和蔗糖]英文名称:Murashige & Skoog Medium without Agar and Sucrose
高氏合成一号夜体培养基英文名称:Gauze’s Synthetic Broth Medium
抗生素培养基39号英文名称:Medium39
赖安酸培养基英文名称:Lysine Medium
细菌L型分离琼脂培养基英文名称:L-Bacterial Isolation Agar
抗生素培养基19号英文名称:Medium 19
碎肉葡萄糖肉汤培养基英文名称:Chopped Meat Glucose(CMG)
"